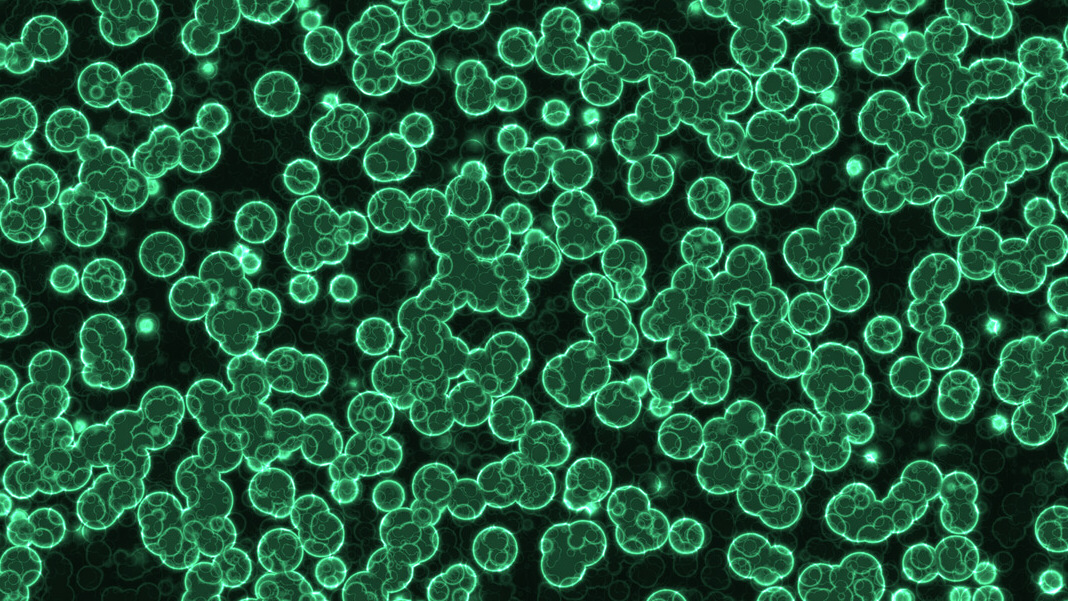

-
'미생물'의 분류와 진화과학(Science)/생명 과학 (Life Science) 2021. 7. 22. 05:07
0. 목차
- 미생물 분류의 역사
- 최신 생물 분류 방법
- 세균
- 고세균(Archaea)
- 진핵생물
- 세균, 고세균, 진핵생물의 세균의 진화
1. 미생물 분류의 역사
'미생물'은 현미경에 보일 정도로 작은 생물을 가리킨다. 눈으로는 볼 수 없는 아주 작은 생물. 보통 세균, 효모, 원생동물 따위를 이르는데, 바이러스를 포함하는 경우도 있다. '대장균'이나 '비피더스균(Lactobacillus bifidus)' 등의 '세균(bacteria)', 얼핏 보면 세균과 비슷하지만 가혹한 환경에서도 보이는 '고세균', 그리고 효모나 버섯 등의 '균류', 아메바나 유글레나 같은 '원생생물' 등이 모두 미생물에 포함된다.
- 2계설(식물계, 동물계) - 린네의 분류법: 그러면 미생물들을 어떻게 분류해야 할까? 그전에 수많은 생물들을 어떻게 분류해야 할까? 최초로 생물의 분류를 시도한 사람은 스웨덴의 식물학자 '칼 폰 린네(Carl von Linné, 1707~1778)'였다. 린네는 계(Kingdom), 문(Phylum), 강(Class), 목(Order), 과(Family), 속(Genus), 종(Species)이라는 생물의 계층을 만들었다. 최상위 계층인 계에는 동물계와 식물계를 만들어 그 가운데 하나의 계로 분류되도록 하였다. 동물과 식물의 차이는 분명하므로 이렇게 나누는 것은 간단한 일처럼 보인다. 하지만 생물 중에는 광합성을 하는 식물의 특징과 자유롭게 이동하는 동물의 특징을 모두 가진 것 생물도 있고, 양쪽 모두 갖지 않은 생물, 시기에 따라 성질이 바뀌는 생물도 있어서 분류하기가 어려웠다.
- 3계설(식물계, 동물계, 원생생물계): 그래서 1866년, 독일의 생물학자 '에른스트 헤켈(1834~1919)'이 린네가 설계한 동물계와 식물계 이외에 '원생생물계'라는 계를 만들었다. 여기에는 동물이나 식물이라고 확실히 말할 수 없는 성질을 가진 세균, 원생생물, 균류 등이 포함되었다.
- 4계설(식물계, 동물계, 원생생물계, 모네라계): 그 후 현미경의 진보 등에 따라, 생물의 몸을 만드는 기본 단위인 '세포'의 구조와 기능이 자세히 조사되었다. 그리고 모든 세포는 '진핵 세포', '원핵 세포' 두 가지 유형으로 나누어진다는 사실이 밝혀졌다. 또 생물의 몸을 만드는 세포의 종류에 따라 원핵생물과 진핵생물로 나누어진다는 사실도 밝혀졌다. 이어 1956년, 미국의 생물학자 '린 마굴리스(Lyn Margulis, 1938~2011)' 등이 원핵생물, 즉 세균을 진핵생물과 구분하기 위해 '모네라계(monera: 모든 원핵생물, 즉 세균)', 원생생물계(protist)', '식물계(plantae)', '동물계(Animalia)'의 4계를 만들었다.
- 5계설 (식물계, 동물계, 원생생물계, 진균계, 모네라계): 1969년, 미국의 생물학자 '로버트 휘태커(Robert Whittaker, 1920~1980)'는 생물의 사체를 분해해 영양분을 얻는 균류를 하나의 독립된 계로 나누어야 한다고 생각했다. 그래서 원생생물계를 균류만으로 만든 균류계와, 그 밖의 원생생물계로 나누었다. 이리하여 식물계, 동물계, 원생생물계, 균류계, 식물계, 동물계로 이루어지는 5계설이 만들어졌다.
- 3도메인 (three-domain system): 하지만 이후 생물의 유전 정보가 분석되자, 모네라계 세균 가운데 다른 세균들과는 다른 유전 정보를 가진 무리가 발견되었다. 이들은 극한 환경에서 발견된 것이 많았기 때문에 '원시 지구와 비슷한 환경에서 사는 세균'이라는 의미에서 '고세균'이라고 명명되었다. 그 후 유전학적 측면에서 고세균은 진핵생물에 가깝다는 사실이 알려졌다. 이에 고세균을 세균 속에 포함시키지 않고 독립된 하나의 무리로 하자는 제안이 나왔다. 현재는 '계(Kingdom)' 위에 '도메인(domain)'이라는 그룹이 만들어졌으며, '모네라계(Monera)'는 일반적인 세균으로 분류되는 '박테리아 도메인(과 '고세균' 도메인으로 갈라졌다.

생물의 분류 2. 최신 생물 분류 방법
현재 모든 생물은 유전 정보로 바탕으로, 크게 3개의 그룹으로 나눌 수 있다. 바로 '세균(Bacteria)', '고세균(Archaea)', '진핵생물(Eukaryota)'이다. 공통 선조로부터 고세균과 세균이 먼저 갈라졌고, 진핵생물은 고생물에서 진화했다. 또 세균, 고세균은 모두 단세포 생물이다.
세균과 고세균 모두 공통 선조에 가까울수록 고온 환경에서 생존 가능한 것이 많다. 그렇기 때문에 '첫 생명체(LUCA)'는 '열수(熱水; 마그마가 식어서 여러 가지 광물 성분이 굳어서 나온 뒤에 남는 수용액)' 환경에서 탄생했다고 생각된다.

3. 세균
3-1. 세균의 구조
세균은 '단세포 생물(하나의 세포로 이루어진 생물)'로, 세포 분열을 통해 증식한다. '모네라계(원핵생물)'에는 '세균'과 '고세균'이 있는데, '모네라계(원핵생물)'는 염색체가 핵막에 덮여 있지 않고, 진핵생물들이 가지고 있는 '미토콘드리아'나 '엽록체' 등의 세포소기관도 없다. 그리고 진핵 세포와 비교했을 때 또 다른 특징은 세균이 '펩티도글리칸(peptidoglycan)'이라는 세포벽을 가지고 있다는 것이다. 이처럼 세균의 세포는 진핵생물에 속하는 사람의 세포와는 모양이 전혀 다르다.
3-2. 그람 양성균, 그람 음성균
이 세균들은 염색액으로 염색할 때 염색되는 방식에 따라 '그람 양성균(Gram Positive)'과 '그람 음성균(Gram Negative)'으로 나누어진다. 그람 양성균은 세포막 밖에 그람 음성균의 것보다 두꺼운 '펩티도글리칸(Peptidoglycan: 세포벽의 일종)'의 층을 가지고 있다. 이 구조 차이는 '겐티안 바이올렛(Gentian Violet)' 등의 색소로 염색했을 때 그 결의 차이로 나타나게 된다. 그람 양성균은 짙은 보라색으로 염색된 후 쉽게 탈색되지 않는 데 반해, 그람 음성균은 염색된 후 쉽게 탈색된다. 그래서 예전에는 세균이 염색되는 상황에 따라 전염병의 원인균을 어느 정도 판단했다.

'그람 양성균'과 '그람 음성균' 3-3. 세균의 분류
그러면 세균에는 어느 정도의 종이 있고 어떻게 분류되고 있을까? 세균의 분류는 1872년, 독일의 박물학자인 '페르디난트 콘(Ferdinand Cohn, 1828~1898)'에 의해 처음 이루어졌다. 그는 세균을 모양에 따라 4종으로 분류했다. 얼마 있다가 세균의 분류에는 현미경으로 모양을 관찰하는 방법에 덧붙여, 효소의 작용 방법이나 영양원을 조사하는 방법이 필요하다고 알려졌다.
3-3-1. rRNA 분석
그리고 1990년 미국의 미생물학자인 '칼 우즈(1928~2012)' 등이 세균이 가지고 있는 'rRNA'끼리 비교해 세균을 분류하는 방법을 제안하였다. rRNA란 '리보솜'의 부품이 되는 유전 물질이다. 생물이라면 모두 다 rRNA를 가지고 있으며, 생물 사이의 차가 적어 분석하기 쉬워서, 유전학적으로 생물을 분류하거나 진화 계통수를 만들 때 이용하게 되었다. 우즈의 제안 뒤, 연구자들이 세균의 rRNA를 조사함으로써 데이터베이스가 구축되어 갔다. rRNA의 데이터베이스를 조회함으로써 어느 세균과 근연인지를 판단할 수 있게 되었다.
현재도 세균을 분류하는 1단계로 rRNA를 분석한 후, 현미경으로 모양을 관찰하거나, 세포벽이나 세포막을 조사하거나, 영양분 섭취 방법, 효소 작용 방법 등을 조사한다. 세균을 분류하기 위해서는 유전학적 방법(rRNA를 비교하는 분석) 뿐만 아니라 생화학적, 생리학적 분석을 할 필요가 있다.
3-3-2. 100만 종 이상의 세균이 있다고 추정됨
세균이 신종으로 인정받기 위해서는 위의 분석에 덧붙여, 발견자와는 다른 사람이 그 세균을 배양할 수 있어야 한다. 이런 검증 과정을 거쳐 인정받은 세균의 종수는 극히 일부이다. 그중 계통 관계가 확실히 알려진 문(門)에 대해 계통수를 그린 것이 아래 그림이다. 아직 배양에 성공하지 못했거나 발견되지 않은 세균을 합치면 자연계에는 100만 종이 넘는 세균이 있으리라고 추정된다. 즉, 현재 인정받고 있는 세균은 자연계에 존재하는 전체 세균의 극히 일부다. 인정된 '종'만을 보아도, 그 살아가는 방식이 다종다양하다. '산소를 좋아하는 세균(호기성 세균)'이 있는가 하면, '산소를 싫어하는 세균(혐기성 세균)'도 있고, 세균의 다수는 중간 온도에서 살아가지만, '열수의 샘' 등 초고열 환경에서 서식하는 세균도 있다. 그리고 바다, 민물, 토양, 동물의 소화관 등에 이르기까지 실로 넓은 범위를 서식처로 삼고 있다. 영양을 섭취하는 방법도 여러 가지이다. 식물처럼 산소를 만들어내는 광합성을 하는 세균도 있지만, 산소를 만들지 않고 광합성을 하는 세균도 있고, 동물처럼 유기물을 분해하는 세균도 있으며, 암모니아나 황, 황산 등의 무기물을 분해해서 영양분을 섭취하는 세균도 있다.

세균의 계통수 4. 고세균(Archaea)
4-1. 고세균의 구조
고세균은 세균과 마찬가지로 '원핵생물'이다. 세균과 고세균은 아주 비슷한 구조를 가지고 있다. 그러면 세균과 고세균은 뭐가 다를까?
- 세포막: 막의 구조를 자세히 살펴보면, 세균은 지질의 이중 구조를 갖지만, 고세균의 경우는 지질이 단층이다. 이 구조 때문에 세균의 세포막은 유연성이 있고, 고세균의 세포막은 조밀하고 단단하다. 즉, 고세균의 세포막이 세포 안의 환경을 외부로부터 더 강력하게 지키고 있다. 고세균 중에는 고온이나 강산 등의 극한 환경에서 서식하는 것들이 많다. 이 때문에 세포 내부 환경을 외부로부터 확실하게 격리시키는 것이 중요하다. 예컨대, 영양분이 매우 부족한 환경에서는 세포 안에 저장된 영양분이 외부로 흘러나가지 않도록 하는 것이 중요하다. 고세균에서 보이는 세포막의 조밀한 구조는 이러한 상황에서 유리하다.
- 세포벽: 세포와 고세균은 세포막의 바깥쪽 구조에도 차이가 있다. 세균은 세포막의 바깥쪽에 펩티도글리칸의 세포벽을 갖고 있지만, 고세균의 다수에는 펩티도글리칸과 비슷한 '슈도뮤레인(Pseudomurein)'이라는 물질로 이루어진 'S층'이라는 세포벽이 있다. 하지만 세포막 바깥에 아무것도 없는 것도 있다.
4-2. 고세균의 분류
고세균은 고온, 강산성, 고염 농도 등 보통의 생물이 살아갈 수 없는 가혹한 환경에서 발견된 것이 많다. 하지만 많은 생물이 살아가는 해양이나 토양, 생물의 소화관에 서식하는 것도 있어, 서식 범위는 넓다. 고세균의 몇 가지 무리를 살펴보자.
- 생태에 특징에 따라: 고세균은 생태의 특징에서 몇 가지 무리로 나누어진다. 하나는 '초호열균'으로, 최적의 서식 온도는 80℃ 이상이다. 온전이나 바닷속의 열수 분출공 등에 서식한다. 또 하나는 '호산성균'이다. 피크로필루스속은 'pH0'에서도 서식할 수 있다. 또 하나의 무리는 고도 호염군 무리로, 소금 농도가 15~30%로 높은 곳에 서식한다.
- 영양분 흡수 방법에 따라: 영양분 흡수 방법에 따라 특징을 나타내는 그룹도 있다. 메탄 생성균은 유기 물질을 분해해 메탄을 만들고 에너지를 얻는 고세균이다. 혐기성으로 논의 토양, 호수나 못의 진흙 바닥, 소 등의 반추 동물이나 흰개미의 소화관에 서식한다.
5. 진핵생물
지금부터는 사람을 포함한 진핵생물을 살펴보자. 진핵생물은 모두 진핵세포로 이루어져 있다. 원핵세포와 비교했을 때, 진핵세포에서 가장 두드러지는 특징은 '핵막'과 '세포 소기관'이 있다는 것이다. 원핵세포와 마찬가지로 진핵세포는 '세포막'에 둘러싸여 있다. 그리고 그 안에는 물 이외의 여러 가지 물질로 가득 차 있다. 그중 가장 중요한 것은 긴 사슬 모양의 분자인 'DNA'다. DNA는 모든 생물의 세포에서 공통되는 요소로, 세포에게 반드시 필요한 각종 단백질을 합성하기 위한 설계도다.
진핵생물(동물, 식물, 균류)의 세포는 DNA를 핵막으로 감싸서 소중하게 보호한다. 핵막에 감싸인 영역을 '세포핵'이라고 한다. 그리고 세포막으로 에워싸인 부분 가운데 세포핵을 제외한 영역을 '세포질'이라고 한다. 세포질에는 소포체, 골지체, 리소좀, 리보솜, 미토콘드리아 등 다양한 부품이 들어있다. 세포 소기관도 세포질의 일부다. 그리고 세포질 가운데 세포 소기관을 제외한 부분을 '세포질 기질'이라고 한다. 세포질 기질에는 아미노산, 포도당, 각종 이온 등의 물질이 들어있다.
5-1. 식물 세포
식물의 세포도 동물의 세포와 마찬가지로 기본적으로 같은 생명의 메커니즘이 작동한다. 세포 핵에 있는 DNA에서 정보를 복제하고, 그 정보를 바탕으로 리보솜에서 단백질을 합성하며, 만들어진 단백질은 소포체에서 골지체를 거쳐 필요한 장소로 보내진다. 이 과정은 진핵생물에서의 공통 메커니즘이다.
식물 세포가 동물 세포와 다른 점은 식물 세포가 '엽록체'를 가지고 있다는 사실이다. 엽록체는 '광합성'을 하는 세포 소기관으로, 태양광 에너지를 이용해 이산화탄소와 물에서 당을 생산하고 산소를 배출한다. 식물 세포의 세포막 바깥쪽에는 '세포벽'이 있다. 세포벽은 포도당이 이어진 '셀룰로오스'라는 분자가 주성분이다. 세포벽으 식물의 몸을 지탱하는 역할을 맡고 있다.
식물 세포에는 거대한 '액포'가 있는 것도 많다. 액포는 경우에 따라서 식물 부피 대부분을 차지하는 경우도 있다. 액포는 식물이 스스로 움직이지 못하는 성질과 관계가 깊다. 이동할 수 없는 식물은 더 유리한 생육 조건을 위해 몸을 크게 성장시킬 필요가 있었는데, 그러기 위해서는 세포가 큰 것이 유리하다. 실제로 식물 세포는 동물 세포보다 지름이 몇 배 큰 경우가 많다. 액포 몸체의 주성분은 물이라, 큰 노력을 기울이지 않아도 부피를 쌓아올릴 수 있다. 또 액포는 동물 세포의 '리소좀'처럼 세포 안의 불필요한 물질을 분해하는 기능도 가지고 있다.

식물 세포 5-2. 균류
진핵생물은 원생생물계, 균계, 동물계, 식물계로 분류된다. 이 중에서 미생물이 소속된 무리는 '원생생물계'와 '균계'다.
균계에는 '효모', '누룩곰팡이', '푸른 곰팡이', '표고버섯' 등 우리 주변에서 흔히 접하는 균류가 속해 있다. 균류의 특징은 '광합성을 하지 않고, 다른 생물의 사체나 배설물 등의 폐기물 같은 유기물을 분해해 영양분을 얻는다는 점'과 '몸이 균사 등 같은 엽상체(뿌리, 줄기, 잎으로 나누어져 있지 않은 몸)로 되어 있다는 점'이다. 크기와 모양이 전혀 다른 곰팡이와 표고버섯이 같은 무리에 있는 것을 의아하게 생각할 수도 있겠지만, 둘 다 '균류'의 특징을 가지고 있다. 대부분의 '균류'는 다세포지만 효모는 단세포다.
5-2-1. 모든 균류가 진균계에 속한 것은 아니다.
하지만 모든 균류가 진균계에 속한 것은 아니다. 균류 가운데 진균계에 속한 것은 '호상균문, 접합균문, 자낭균문, 담자균문, 불완전 균류이다. 그중 진균계로 분류되는 것을 '진균이라고 한다. 휘태커가 5계설을 제안할 당시 균류는 모두 균류계로 분류되어 있었다. 하지만 이후 rRNA 분석이 이루어진 결과, 진균을 제외한 나머지 균류는 계통적으로 크게 떨어져 있음이 알려져 다른 무리로 구분하게 되었다. 진균계로 분류되지 않는 균류는 원생생물계에 속해 있다. 즉, 균류는 진균계와 원생생물계 모두에 있다.
5-2-2. 진균계의 생식
전형적인 균류인 '진균'의 몸은 '엽상체'로 되어 있다. '엽상체'는 실처럼 긴 '균사'라는 세포가 모인 '균사체'이다. '균사체'에서 헛뿌리 등을 뻗어 생물의 사체나 배설물, 의류 등의 유기물에서 에너지를 흡수한다.
진균의 다수는 무성생식과 유성생식을 해서 증식한다. 무성생식에서는 균사체에서 포자를 날린다. 이 포자가 온도, 습도, 영양분 조건이 갖추어진 장소에 이르면 거기서 균사를 뻗어 성장한다. 그리고 균사가 충분히 성장해 사람 눈에 보이기 시작하면, 우리는 그것을 '곰팡이'라고 인식한다. 유성 생식에서는 균사체에서 방출되는 포자끼리 접합해 배수의 핵을 가진 세포가 된다.
6. 세균, 고세균, 진핵생물의 비교
원핵생물이 진핵생물과 다른 점은 핵막이나 세포 소기관이 없다는 것이다. 이렇게 말하면 원핵생물의 기능이 떨어지는 것처럼 보이지만, 원핵생물은 진핵생물이 할 수 없는 화학 반응을 할 수 있다.
원핵생물인 세균과 고생물이 원핵생물에 속해 둘이 비슷하고, 진핵생물과 전혀 다르다고 생각할 수 있지만 그렇지도 않다. 오히려 고세균은 세균보다 진핵생물에 가깝다. 실제로 rRNA를 유전학적으로 비교해 봤을 때 고세균은 세균보다 진핵생물에 가까웠다. 여러 유전자의 분석 결과에 의해 만들어진 최신 계통 수에서는 진핵생물이 고생물의 하나인 '로키아르카이오타문'에서 파생되었다고 한다.
6-1. 로키아르카이오타문
2015년 북극 중앙 해령의 해저 열수계에서 채취한 시료에서는 새로운 고세균이 발견되었다. 그리고 이 고세균은 유전학적 분석에 의해 지금까지 발견된 고세균 중 가장 진핵생물과 가까운 무리라는 사실이 밝혀졌다. 이 무리 중에 있는 고세균의 모든 게놈을 해독하였더니 진핵생물에 특징적인 유전자를 다른 고세균보다 많이 가지고 있었다.
이 고세균이 가진 기능을 추측함으로써, 진핵생물의 선조가 고세균이라는 설을 설명할 수 있게 되었다. 이 고세균 무리는 시료가 채취된 해저 열수계의 이름을 따 '로키아르카이오타문(Lokiarchaeota)'라고 명명되었다.
7. 세균의 진화
세균은 고세균과 갈라진 뒤 독자적인 진화를 이루었다.
7-1. 사이노박테리아
원래 지금으로부터 약 21억 년 전까지 대기 중에는 산소가 거의 없었다. 그래서 최초에는 산소 호흡이 아니라 황을 사용한 호흡을 하는 세균이 나타난 것 같다. 산소 발생을 수반하지 않는 오래된 형태의 광합성에 의해 에너지를 끌어내는 세균도 있었다. 그 후 광합성을 해서 산소를 만들어 내는 산소 무리인 '남조세균문(시아노박테리아)'가 등장해 지구의 환경이 극적으로 변한 것으로 생각된다. 태양의 빛과 물, 이산화탄소, 무기물이 있으면 살아갈 수 있는 이 세균은 지구 규모로 번식해 수억 년 사이에 지구의 대기 중의 산소를 20%까지 늘렸다.
산소를 이용해 유기물을 분해할 수 있는 세균이 나타난 이후, 지구에는 다종다양한 생물의 탄생으로 이어지는 극적인 사건이 일어나게 된다. 바로 진핵생물이 탄생한 것이다.
사이노박테리아(Cyanobacteria) 7-2. 세포 내 공생설
1967년, 미국의 생물학자 '린 마굴리스(Lynn Margulis, 1938~2011)'는 동물과 식물의 세포는 세균을 세포 내부에서 살게 하면서 진화했다고 생각하는 '세포 내 공생설'을 발표했다. 이 설에 따르면 지금으로부터 20억~10억 년 전에 고세균이 세균을 내부로 흡수했다. 내부로 들어간 세균은 산소를 사용해 유기물을 분해하고 에너지를 획득하는 능력을 가지고 있었다. 이렇게 해서 고세균은 몸속으로 흡수한 세균에게 효율적으로 에너지를 만드는 '산소 호흡'을 맡기게 되었다. 내부에서 살게 된 세균도 고세균의 몸속에 있는 것만으로 영양분을 공급받을 수 있었다. 이로써 서로가 이익을 얻는 '공생 생활'을 시작하게 된 것이다.
이후 고세균과 세균이 융합한 이 생물은 동물의 세포가 되었고, 내부에서 서식하게 된 세균은 세포 안에서 에너지를 만드는 세포 소기관인 '미토콘드리아(Mitochondria)'가 되었다. 그리고 사이노박테리아를 흡수한 고세균은 광합성을 할 수 있는 세포가 되었다. 이 생물은 식물 세포로 진화하였고, 흡수된 '사이노박테리아(Cynobacteria)'는 '엽록체(Chloroplast)'가 되었다.